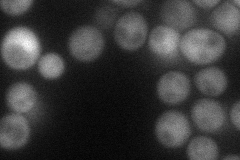
YOL159C-A
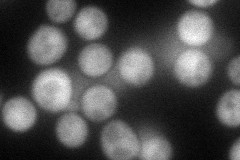
YOL159C-A
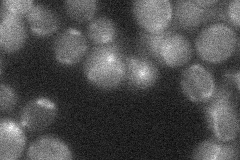
YOL159C-A
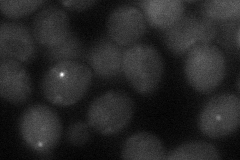
YOL159C-A
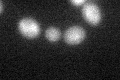
YOL159C-A
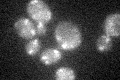
YOL159C-A

View description
Putative protein of unknown function; identified by sequence comparison with hemiascomycetous yeast species
Localization:
Intensity:
Fold change:
Significance:
-
C’ GFP library in SD

below threshold17.64 -
N' NOP1pr-GFP in SD
cytosol49.7519 -
N' TEF2pr-mCherry in SD
cytosol66.466 -
N' NATIVEpr-GFP in SD
below threshold18.2185 -
N' TEF2pr-VC and Cyto-VN in SD
cytosol,punctate31.6228 -
C’ GFP library in SD+DTT
cytosol18.111.02No -
C’ GFP library in SD+H2O2
cytosol16.60.94No -
C’ GFP library in Starvation Media

cytosol16.170.91No -
C’ GFP library on the background of Pup2-DaMP

below threshold -
C’ GFP library on the background of CCT mutant

below threshold16.10960.912902No
